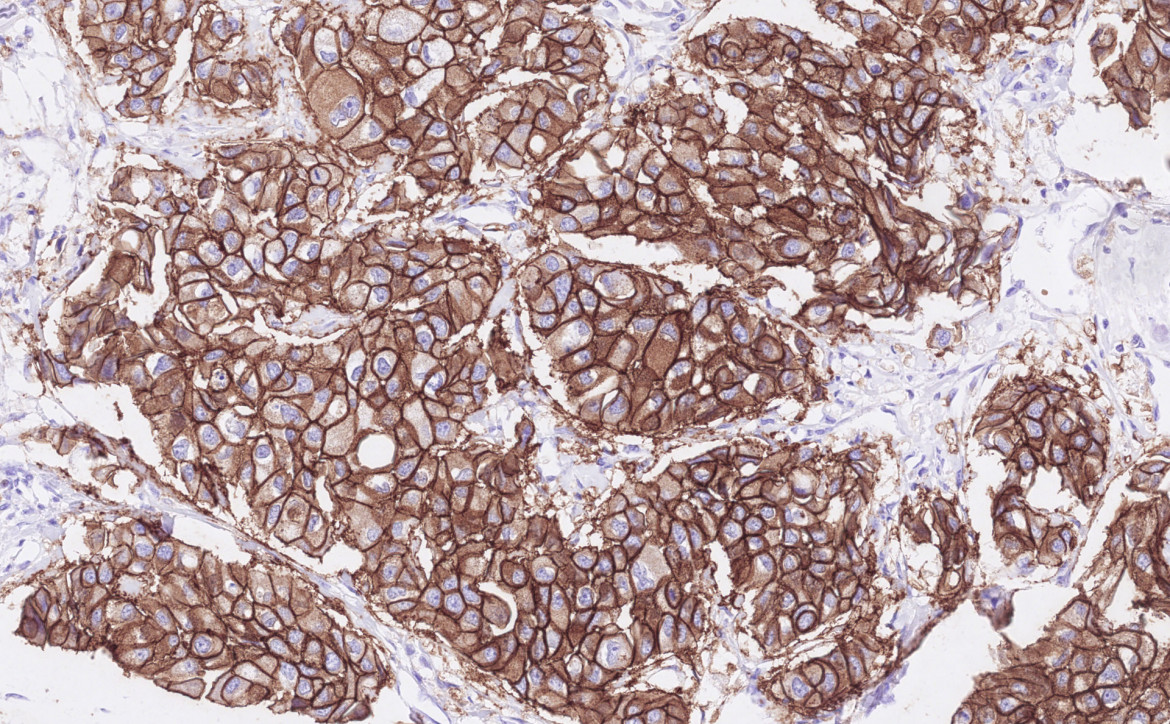
anatomo-pathologie à l'ICM

Le département d’Anatomie et Cytologie Pathologiques de l’ICM a pour mission d’établir le diagnostic formel de lésion tumorale et d’en préciser les caractéristiques morphologiques (lésion bénigne, maligne, degré d’agressivité, limites d’exérèse d’une tumeur). Ce diagnostic peut s’établir à partir de pièces opératoires, de biopsies ou de prélèvements cytologiques. Les examens sont réalisés à la demande de médecins de différents services. En cancérologie, ce diagnostic est indispensable avant de débuter tout traitement.
Le rôle de l'anatomie pathologique
De plus, le département d'anatomie pathologique est impliqué dans la détermination de facteurs prédictifs de réponse ou de résistance à un traitement donné (notamment concernant les thérapies ciblées). En d’autres termes, il a pour but de définir le bon traitement pour le bon patient. L’ensemble de ces éléments s’établit à partir de techniques complémentaires.
A la pointe de l’innovation technologique (technique d’hybridation in situ par fluorescence (FISH), « pathologie numérique », etc…), le département d’Anatomie pathologique de l’ICM a une expertise particulière en pathologie tumorale mammaire, digestive, gynécologique et en pathologie tumorale des tissus mous et des viscères (sarcomes).
Les médecins pathologistes de l’ICM sont des référents nationaux dans leur domaine et font partie de groupes d’experts français :
- Réseau de Référence en Pathologie des Sarcomes des tissus mous et des viscères (RRePS)
- Tumeurs Malignes Rares de l'Ovaire (TMRO)
- Groupe d’Etude des Facteurs Pronostiques Immunohistochimiques dans le Cancer du Sein (GEFPICS)
- Association Française d’Assurance Qualité en Anatomie et Cytologie Pathologiques (AFAQAP)
Le service étant situé géographiquement juste à côté du bloc opératoire, le transfert des pièces chirurgicales est très rapide et le dialogue entre chirurgiens et pathologistes est facilité.
Le service d’anatomie et cytologie pathologiques est le maillon essentiel qui permet de faire le lien entre la clinique (participation d’un médecin pathologiste à chaque RCP de l’ICM), la recherche clinique (CRB), la recherche translationnelle (URT) et la recherche fondamentale (IRCM), tous situés sur le même campus.
Le service de l’ICM possède également des liens étroits avec les autres laboratoires d’anatomie et cytologie pathologiques de toute l’Occitanie, en travaillant notamment en coordination avec le CHU de Montpellier et le CHU de Nîmes et avec l’Oncopôle de Toulouse.
Le département est composé de 32 personnes avec des compétences pluridisciplinaires : 8 médecins séniors, deux internes, une cadre, une chef d’équipe, 17 techniciens de laboratoires et 3 secrétaires.
Les prélèvements
Les prélèvements (biopsies, pièces opératoires, liquides de ponction) sont adressés au service d’anatomie et cytologie pathologiques, par les différents services de l’institut (radiologie, chirurgie, endoscopie, hospitalisations etc…), afin d’y être examinés.
- Une biopsie est un petit fragment de tissu prélevé par voie trans-cutanée (à travers la peau) au sein du service d'imagerie médicale, ou par voie endoscopique (au cours d’un examen permettant d’explorer l'intérieur d'un organe creux ou d’une cavité). Il s’agit en général d’un échantillon de tumeur.
- Les pièces opératoires correspondent à des exérèses partielles ou complètes d'un ou de plusieurs organes, prélevées au bloc opératoire par le/la chirurgien(ne), au cours d’une opération chirurgicale.
- Les liquides de ponction sont des liquides recueillis par aiguilles : il peut s’agir par exemple de liquide d’ascite, de liquide pleural, de liquide céphalo-rachidien (LCR) etc…

L’examen des pièces opératoires
Dans le service, les pièces opératoires subissent un examen macroscopique (examen à l’œil nu) permettant leur mesure, leur pesée et leur description (présence d’une tumeur visible). Si la tumeur est assez volumineuse, un petit fragment tumoral sera congelé et conservé au sein de la tumorothèque de l’ICM.
La tumorothèque a un rôle sanitaire et scientifique. Ainsi les prélèvements permettent, après information du patient, de réaliser des collections biologiques destinées à des projets de recherche clinique, translationnelle ou plus fondamentale.
L'examen microscopique
Les différents prélèvements subissent ensuite de multiples étapes techniques (fixation en formol, déshydratation, inclusion en paraffine, coupe au microtome), réalisées par les techniciens de laboratoire, s’effectuant sur plusieurs jours. Ces étapes permettent d’obtenir au final des coupes très fines (3 ou 4 microns d’épaisseur), colorées ("colorations standards" : Hématoxyline Eosine Safran - HES - à l’ICM), posées sur des lames de verres et observables au microscope.

Un des médecins pathologistes de l’institut, expert en cancérologie, examine ces lames au microscope (examen microscopique) et doit déterminer :
- si ce prélèvement renferme des cellules tumorales ou pas,
- si oui : s’il s’agit d’une tumeur maligne ou bénigne.
S’il s’agit d’une tumeur maligne (cancer), le médecin pathologiste doit alors apporter de multiples précisions. En effet, chaque cancer est différent et a ses propres caractéristiques.
Il déterminera par exemple :
- le type histologique précis (très nombreux types de cancers possibles, pouvant être très différents en fonction de l’organe atteint)
- le grade ("agressivité" de la tumeur)selon différents référentiels variables en fonction de l’organe atteint
- le stade (extension de la maladie) : taille tumorale précise, extension (métastase) aux ganglions ou pas, extension (métastase) à distance ou pas, présence de cellules tumorales dans les vaisseaux (embols) ou pas,…
- sur les pièces opératoires, la distance aux berges chirurgicales
- si la chirurgie a été faite après traitement (exemple : après chimiothérapie néoadjuvante), le degré de réponse de la tumeur à ce traitement.
- la présence de caractères très spécifiques de la tumeur lui permettant d’être sensible à certains traitement ciblés (exemple : un cancer du sein exprimant les récepteurs hormonaux sera sensible à un traitement anti-hormonal, alors que s’il ne les exprime pas, ce traitement ne sera pas efficace sur la tumeur). Il s’agit de facteurs théranostiques.
Les lames de verre et les blocs de paraffine sont conservés dans des archives pendant plusieurs années.

Les techniques complémentaires
Afin de l’aider dans son diagnostic, le médecin pathologiste peut faire appel à des techniques spécifiques complémentaires : colorations spéciales, immunohistochimie, hybridation in situ, biologie moléculaire.

Le compte-rendu
Pour finir, le médecin pathologiste compile l’ensemble de ces données dans un compte-rendu de pathologie.
Grâce à l’ensemble de ces renseignements sur la maladie cancéreuse, le médecin oncologue qui suit le patient pourra ainsi déterminer le meilleur traitement, le plus adapté et le plus efficace, pour ce cancer précis, chez ce patient en particulier (médecine personnalisée).
L’examen extemporané
Parfois, il sera demandé au service d’anatomie et cytologie pathologiques d’effectuer l’examen d’un prélèvement de manière beaucoup plus rapide et de donner un résultat en quelques minutes, durant l’opération du patient, afin de guider le geste opératoire du chirurgien : il s’agit d’un "examen extemporané".